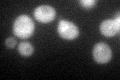
YPL116W
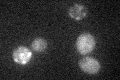
YPL116W

View description
Trichostatin A-insensitive homodimeric histone deacetylase (HDAC) with specificity in vitro for histones H3, H4, H2A, and H2B; similar to Hda1p, Rpd3p, Hos1p, and Hos2p; deletion results in increased histone acetylation at rDNA repeats
Localization:
Intensity:
Fold change:
Significance:
-
C’ GFP library in SD

bud neckN/A -
N' NOP1pr-GFP in SD

cytosol,bud neck74.6819 -
N' TEF2pr-mCherry in SD

cytosol69.906 -
N' NATIVEpr-GFP in SD

bud neck33.2708 -
N' TEF2pr-VC and Cyto-VN in SD

cytosol50.486 -
C’ GFP library in SD+DTT
bud neck33.81.14No -
C’ GFP library in SD+H2O2

bud neck33.81.14No -
C’ GFP library in Starvation Media
bud neck28.930.97No -
C’ GFP library on the background of Pup2-DaMP

bud neck -
C’ GFP library on the background of CCT mutant

bud neck32.97631.11505No
